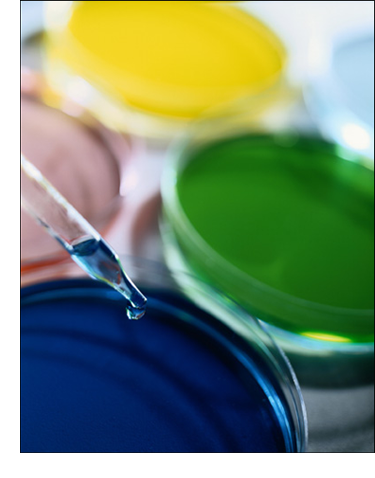

About Us
YEE LEE PTE LTD is the appointed distributor of DOW CHEMICAL Company. We provide a wide range of chemical and plastic products to cater to various markets. Some of the other chemical company products distributed by YEE LEE are BASF, Momentive, Evonik, Huntsman, Tosoh and Florida Chemicals.
Founded since 1980, YEE LEE is committed to providing reliable, prompt and quality services to our clients. We serve a clientele ranging from small medium enterprises to global organizations.
With many years of experience in the polyurethane and chemical industry, we have the expertise and resources to meet your various needs.
Contact us for your enquiries. We will be glad to assist you.